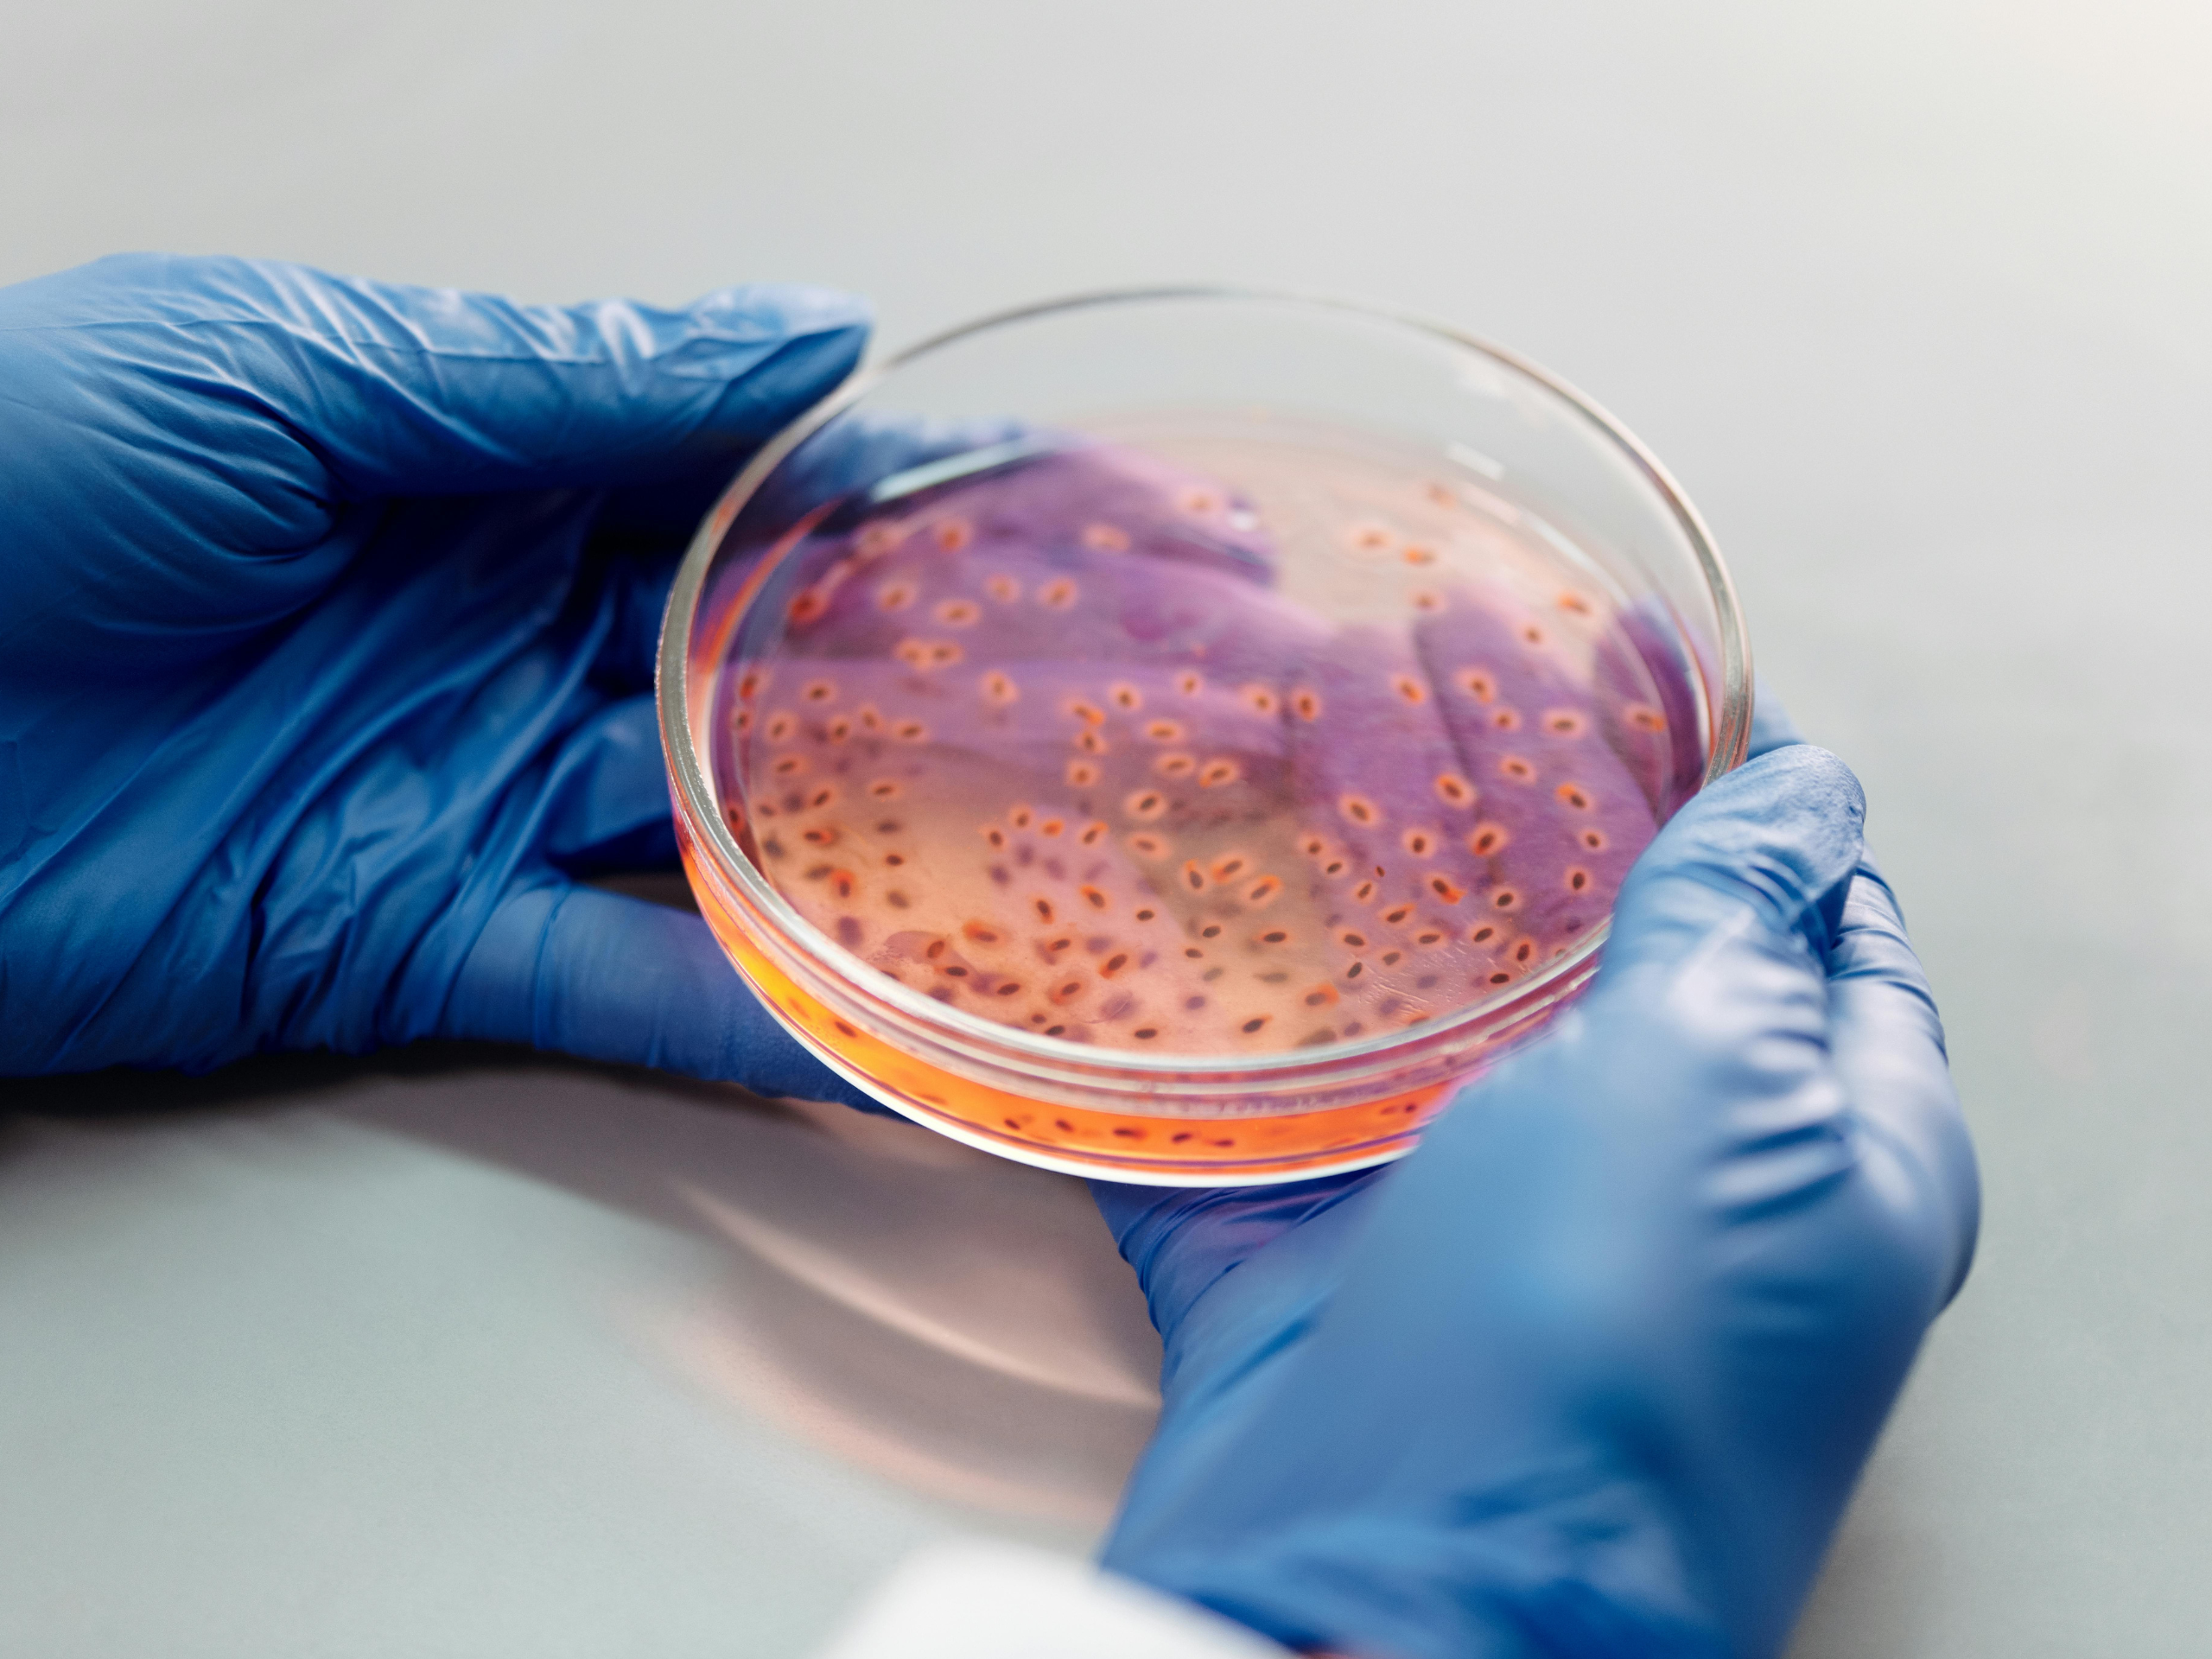

Soluciones innovadoras para la salud
Desde terapias de vanguardia hasta soluciones nutricionales, descubre nuestros productos innovadores para prevenir, tratar y mejorar tu calidad de vida.
Descubre cómo nuestras soluciones en inmunoterapia y nutrición terapéutica pueden ayudarte a prevenir, tratar y mejorar tu salud desde dentro

Inmunoterapía Alergénica
Tratamientos de precisión que modulan la respuesta inmunitaria para lograr una tolerancia duradera frente a alérgenos específicos.
Descubre nuestros tratamientos
Inmunoterapía Bacteriana
Soluciones innovadoras que fortalecen el sistema inmunológico y ayudan a prevenir infecciones recurrentes.
Cómo fortalecemos tus defensas

Nutrición terapéutica
Formulaciones especializadas que apoyan el tratamiento médico y contribuyen a mejorar la calidad de vida del paciente.
Conoce nuestras soluciones nutricionales
¿Si tienes alguna pregunta sobre tus síntomas o necesitas orientación, no dudes en contactar con nuestros especialistas en alergias. ¡Estamos aquí para ayudarte!

Contacta con nosotros
Si buscas orientación sobre tu tratamiento o quieres conocer la mejor opción para tu salud, nuestro equipo de especialistas está aquí para ayudarte en cada paso.
Contáctanos
